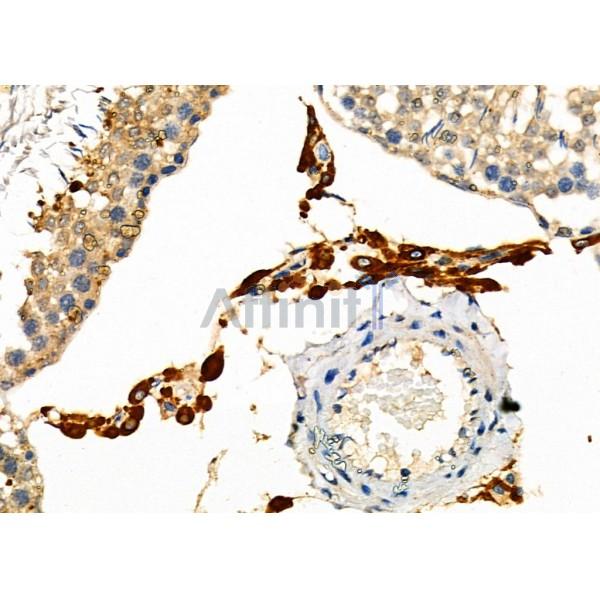
CASK Antibody - DF6970 at 1/100 staining Rat testis tissue by IHC-P.

CASK Antibody - #DF6970
| Product: | CASK Antibody |
| Catalog: | DF6970 |
| Description: | Rabbit polyclonal antibody to CASK |
| Application: | WB IHC |
| Reactivity: | Human, Mouse, Rat |
| Prediction: | Bovine, Horse, Rabbit, Chicken, Xenopus |
| Mol.Wt.: | 105kDa; 105kD(Calculated). |
| Uniprot: | O14936 |
| RRID: | AB_2838926 |
Related Downloads
Protocols
Product Info
*The optimal dilutions should be determined by the end user. For optimal experimental results, antibody reuse is not recommended.
*Tips:
WB: For western blot detection of denatured protein samples. IHC: For immunohistochemical detection of paraffin sections (IHC-p) or frozen sections (IHC-f) of tissue samples. IF/ICC: For immunofluorescence detection of cell samples. ELISA(peptide): For ELISA detection of antigenic peptide.
Cite Format: Affinity Biosciences Cat# DF6970, RRID:AB_2838926.
Fold/Unfold
CAGH39; Caki; Calcium/calmodulin dependent serine protein kinase; Calcium/calmodulin dependent serine protein kinase (MAGUK family); Calcium/calmodulin dependent serine protein kinase membrane associated guanylate kinase; Calcium/calmodulin-dependent serine protein kinase; CAMGUK; CAMGUK protein; CAMGUK, drosophila, homolog of; casK; CMG; CSKP_HUMAN; DXPri1; DXRib1; FGS4; FLJ22219; FLJ31914; hCASK; LIN 2; Lin 2 homolog; LIN2; Lin2 homolog; MICPCH; MRXSNA; Pals3; Peripheral plasma membrane protein CASK; Protein lin-2 homolog; TNRC8; Trinucleotide repeat containing 8; Vertebtate LIN2 homolog;
Immunogens
A synthesized peptide derived from human CASK, corresponding to a region within the internal amino acids.
Ubiquitous. Expression is significantly greater in brain relative to kidney, lung, and liver and in fetal brain and kidney relative to lung and liver.
- O14936 CSKP_HUMAN:
- Protein BLAST With
- NCBI/
- ExPASy/
- Uniprot
MADDDVLFEDVYELCEVIGKGPFSVVRRCINRETGQQFAVKIVDVAKFTSSPGLSTEDLKREASICHMLKHPHIVELLETYSSDGMLYMVFEFMDGADLCFEIVKRADAGFVYSEAVASHYMRQILEALRYCHDNNIIHRDVKPHCVLLASKENSAPVKLGGFGVAIQLGESGLVAGGRVGTPHFMAPEVVKREPYGKPVDVWGCGVILFILLSGCLPFYGTKERLFEGIIKGKYKMNPRQWSHISESAKDLVRRMLMLDPAERITVYEALNHPWLKERDRYAYKIHLPETVEQLRKFNARRKLKGAVLAAVSSHKFNSFYGDPPEELPDFSEDPTSSGLLAAERAVSQVLDSLEEIHALTDCSEKDLDFLHSVFQDQHLHTLLDLYDKINTKSSPQIRNPPSDAVQRAKEVLEEISCYPENNDAKELKRILTQPHFMALLQTHDVVAHEVYSDEALRVTPPPTSPYLNGDSPESANGDMDMENVTRVRLVQFQKNTDEPMGITLKMNELNHCIVARIMHGGMIHRQGTLHVGDEIREINGISVANQTVEQLQKMLREMRGSITFKIVPSYRTQSSSCERDSPSTSRQSPANGHSSTNNSVSDLPSTTQPKGRQIYVRAQFEYDPAKDDLIPCKEAGIRFRVGDIIQIISKDDHNWWQGKLENSKNGTAGLIPSPELQEWRVACIAMEKTKQEQQASCTWFGKKKKQYKDKYLAKHNAVFDQLDLVTYEEVVKLPAFKRKTLVLLGAHGVGRRHIKNTLITKHPDRFAYPIPHTTRPPKKDEENGKNYYFVSHDQMMQDISNNEYLEYGSHEDAMYGTKLETIRKIHEQGLIAILDVEPQALKVLRTAEFAPFVVFIAAPTITPGLNEDESLQRLQKESDILQRTYAHYFDLTIINNEIDETIRHLEEAVELVCTAPQWVPVSWVY
Predictions
Score>80(red) has high confidence and is suggested to be used for WB detection. *The prediction model is mainly based on the alignment of immunogen sequences, the results are for reference only, not as the basis of quality assurance.
High(score>80) Medium(80>score>50) Low(score<50) No confidence
Research Backgrounds
Multidomain scaffolding protein with a role in synaptic transmembrane protein anchoring and ion channel trafficking. Contributes to neural development and regulation of gene expression via interaction with the transcription factor TBR1. Binds to cell-surface proteins, including amyloid precursor protein, neurexins and syndecans. May mediate a link between the extracellular matrix and the actin cytoskeleton via its interaction with syndecan and with the actin/spectrin-binding protein 4.1.
Nucleus. Cytoplasm. Cell membrane>Peripheral membrane protein.
Ubiquitous. Expression is significantly greater in brain relative to kidney, lung, and liver and in fetal brain and kidney relative to lung and liver.
The first L27 domain binds DLG1 and the second L27 domain probably binds LIN7.
The protein kinase domain mediates the interaction with FCHSD2.
In the N-terminal section; belongs to the protein kinase superfamily. CAMK Ser/Thr protein kinase family. CaMK subfamily.
Belongs to the MAGUK family.
Restrictive clause
Affinity Biosciences tests all products strictly. Citations are provided as a resource for additional applications that have not been validated by Affinity Biosciences. Please choose the appropriate format for each application and consult Materials and Methods sections for additional details about the use of any product in these publications.
For Research Use Only.
Not for use in diagnostic or therapeutic procedures. Not for resale. Not for distribution without written consent. Affinity Biosciences will not be held responsible for patent infringement or other violations that may occur with the use of our products. Affinity Biosciences, Affinity Biosciences Logo and all other trademarks are the property of Affinity Biosciences LTD.